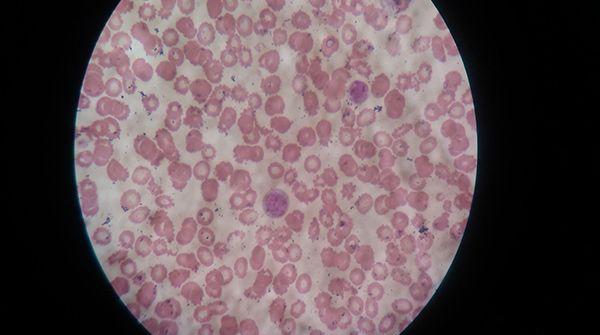

白带常规检查清洁度达3或4度需重视,当心炎症找上门
- 试管婴儿
- 2023-06-08 10:09
白带常规出结果单后,有部分孕妇不解检查单上的清洁度是什么意思,因此孕妇就无法独自通过检查单判断自己目前的身体情况,有的孕妇清洁度是3,有的则是4,这些级别都需要引起重视,稍不注意就能确诊是炎症。
做白带常规可通过清洁度排除炎症
白带常规检查清洁度解意
白带常规清洁度是对阴道分泌物涂片检查的一种方法,通过这项检查可以观察阴道干净程度,确定阴道内是否有特殊的细菌及细胞,一般来说,如果检查清洁度为3或是4度则意味着是阴道炎,女性需要引起重视。
取白带分泌物放在显微镜下观察
通过清洁度这项数据并不能直接确诊女性存在炎症,还需要结合其它各项检查,例如细菌、滴虫、霉菌这些指标是不是阴性,如果是阴性的话,则意味着女性清洁度高是由于特异性感染所致。
妇科炎症患者需要去做白带检查确诊
众所周知白带常规能查出的疾病较多,不仅能查出女性是否患有盆腔炎、宫颈糜烂、宫颈炎等一系列妇科疾病,还可以找出女性月经周期异常的诱因,但要想确诊这些疾病,只能过看清洁度是远远不够的,还需要通过检查单上的其它指标判断。
对于初次做白带常规检查且没有性生活的女性,在做检查前最好是先提前学习一些做白带常规取白带的姿势,处女取白带疼痛感较强烈,但选对取带姿式不仅可以避免疼痛,还可避免影响到清洁度检查准确率。
白带常规清洁度分级标准
临床上对于白带常规清洁度有分级标准,总共可分为四个级别,每一个级别代表着女性阴道内细菌群的大概范围,级别越高意味着细菌群越多,一般来说,清洁度达到3或4级,则意味着女性患有生殖器官方面的炎症。
清洁度级别 分级标准 一度 显微镜下可以看到大量的阴道杆菌以及上皮细胞没有杂菌和白细胞这是正常现象 二度 显微镜下可看到阴道杆菌及上皮细胞,并且有少量的白细胞及杂菌,这是正常的阴道分泌物 三度 有少量的杆菌以及鳞状上皮细胞较多的杂菌,这种现象提示有轻度阴道炎症 四度 没有阴道杆菌,只有少量的上皮细胞,并且有大量的白细胞以及杂菌,这是较为严重的阴道炎症
一般来说,患有盆腔炎、宫颈糜烂、宫颈炎等疾病的女性做白带常规检查后,清洁度会显示3或4度,因此临床上将清洁度认为是排除女性患有妇科炎症的重要依据。说到检查妇科炎症,在其实做tct也是能筛查炎症的,虽然这两项技术所排除的疾病相似,但白带常规和tct的区别非常大,特别是在收费标准上,TCT更贵一些。
白带常规清洁度相关问题
白带常规清洁度3严重吗?
白带常规清洁度3是轻微炎症,一般来需要过于担心,在多数情况下,清洁度三甚至并不能代表女性就有妇科炎症。
白带检查清洁度三度怎么降下来?
白带检查清洁度三度是轻微炎症,如果想要降下来,那么可以先去医院做个全方面的检查,并在医生指导下服用一些消炎类药物,通常情况下服用消炎类药物症状会有所改善,但要注意这并不意味着炎症已痊愈,而是病原体暂时受到了抑制,女性千万不要就此停药,而是坚持按疗程治疗。
白带常规清洁度4度用什么药?
清洁度4可以确诊女性患有炎症的,这个时候女性不要盲目去买药吃,建议应先去医院做检查,因为引起阴道炎症的诱因有很多,需要根据检查结果明确具体原因,然后再对性的进行治疗,治疗妇科炎症的药包括有达克宁栓、克霉唑栓、双唑泰栓、克霉唑软膏、霉菌素栓剂、达克宁栓等。服用这些药的同时,女性要注意不能同房,另外在日常饮食上要多吃一些高蛋白优质蛋白食物,并注意阴部卫生。

发表评论